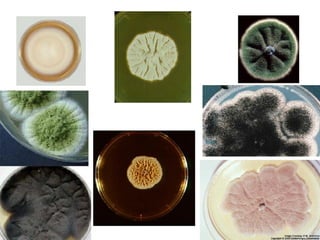
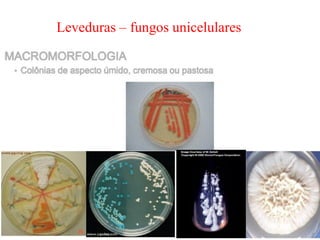
Leveduras – fungos unicelulares
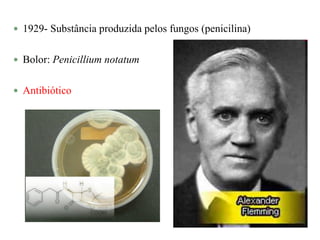
 1929- Substância produzida pelos fungos (penicilina)
 Bolor: Penicillium notatum
 Antibiótico

Este documento fornece informações sobre fungos, incluindo sua classificação no Reino Fungi, características como serem eucariontes aclorofilados e heterótrofos, e formas de reprodução sexuada e assexuada. Detalha também a citologia de fungos, descrevendo estruturas como parede celular, membrana, núcleo e organelas. Apresenta os principais tipos morfológicos de fungos, como bolores, leveduras e cogumelos.